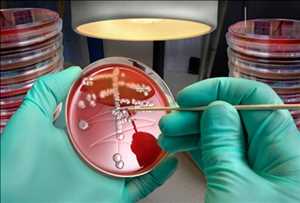
Prueba de E. coli

El informe de mercado de Prueba de E. coli proporciona un análisis en profundidad del mercado global de Prueba de E. coli que comprende la sinopsis general del mercado, las clasificaciones, las aplicaciones, las definiciones y la estructura de la cadena de la industria. El informe ofrecerá información significativa al tiempo que destaca a los actores clave [BioMerieux, InstantLabs, Nanosphere, Mobidiag, Luminex Corporation, Bio-Rad Laboratories, Vivione Biosciences, Pro-Lab Diagnostics, Becton, Meridian Bioscience, QIAGEN, Accugen Laboratories, Alere, Diasorin, EIKEN CHEMICAL, Enzo Life Sciences, Romer Labs] que participan activamente y contribuyen al crecimiento del mercado global de Prueba de E. coli. Además, incluye información proporcionada por analistas y expertos sobre estados financieros, así como perfiles de empresas, productos y servicios de los principales actores del mercado.
El informe incluye los conocimientos presentados sobre los micro mercados que las partes interesadas pueden aprovechar, además de una evaluación detallada del panorama competitivo y las ofertas de productos de los actores clave. El informe de mercado ofrece una perspectiva progresiva sobre varios aspectos que pueden tener el potencial de impulsar u obstaculizar la expansión del mercado global Prueba de E. coli durante el período de pronóstico (2019-2026).
Además, el informe también incluirá la CAGR esperada calculada del mercado Prueba de E. coli sobre la base de los registros actuales e históricos en relación con el mercado global. Además, también ofrece un análisis preciso para alterar la dinámica competitiva del mercado, lo que puede ayudar aún más en la toma de decisiones. También ayuda a reconocer los productos clave y su potencial de crecimiento durante el período proyectado.
Perfil de algunos de los principales actores del mercado incluidos en este informe:
BioMerieux, InstantLabs, Nanosphere, Mobidiag, Luminex Corporation, Bio-Rad Laboratories, Vivione Biosciences, Pro-Lab Diagnostics, Becton, Meridian Bioscience, QIAGEN, Accugen Laboratories, Alere, Diasorin, EIKEN CHEMICAL, Enzo Life Sciences, Romer Labs
Los principales objetivos del informe de investigación de mercado son los siguientes:
Investigue y analice la capacidad, el valor, el consumo, la producción, el estado y el pronóstico del mercado Prueba de E. coli para 2026.
Describir, definir y analizar situaciones competitivas en el mercado y enfocarse en productos competitivos.
Describir, definir y pronosticar el mercado por tipo, aplicación y región.
Investigue y analice las ventajas y el potencial del mercado, las oportunidades futuras, los desafíos y las amenazas en las industrias clave.
Investigar y analizar tendencias de crecimiento específicas y analizar sus contribuciones.
Para obtener una consulta gratuita sobre el informe, haga una consulta aquí @ www.marketresearchstore.com/market-insights/e-coli-testing-market-813200
El informe también involucrará el impacto del coronavirus en curso o la pandemia COVID-19 en la dinámica del mercado. Esta pandemia ha afectado a todas las facetas de la vida en todo el mundo. Así, el informe incluirá un apartado dedicado a analizar la situación teniendo en cuenta el impacto del COVID-19.
Además, el informe clasifica el mercado Prueba de E. coli en varios segmentos y subsegmentos. El informe evalúa y predice además el potencial de expansión de cada segmento para el período proyectado. Además, el informe también divide y evalúa el mercado de Prueba de E. coli en términos generales sobre la base de la geografía.
Américas (Estados Unidos, Canadá, México, Brasil)
APAC (China, Japón, Corea, Sudeste de Asia, India, Australia)
Europa (Alemania, Francia, Reino Unido, Italia, Rusia, España)
Medio Oriente y África (Egipto, Sudáfrica, Israel, Turquía, países del CCG)
Mercado global de Prueba de E. coli por tipo: Consumibles, Instrumentos
Mercado global de Prueba de E. coli por aplicación: Hospital, Clínica
El informe incluye la evaluación de varios factores que influyen en el crecimiento del mercado global, que comprenden la política gubernamental, el entorno del mercado, el panorama competitivo, los datos históricos, las tendencias actuales del mercado, la innovación tecnológica y las próximas tecnologías. , además de los riesgos, oportunidades, desafíos y obstáculos del mercado.
Para concluir, el informe Prueba de E. coli ofrece un análisis metódico del tamaño de la industria, la oferta y la demanda, el volumen de ventas, la importación, la participación, la exportación y el valor del análisis de la cadena. Aparte de esto, el informe contiene datos importantes que pueden ayudar al cliente a tomar decisiones teniendo en cuenta el crecimiento a largo plazo. Con todo, este informe ayudará a ganar reconocimiento con numerosas perspectivas de crecimiento en el mercado global.
Examinar el informe completo antes de la compra @ www.marketresearchstore.com/inquiry/e-coli-testing-market-813200
(También se proporcionará un informe de datos gratuito (como una hoja de cálculo de Excel) a pedido con una nueva compra).
Razones para comprar el Informe de mercado global Prueba de E. coli:
Se proporcionan nuevos canales de marketing y tendencias de desarrollo.
El análisis demográfico y el panorama competitivo brindan una visión clara del estado del mercado en la plataforma global
Mención precisa de fuentes valiosas y datos estadísticos para dirigir a los fabricantes / empresas interesados
El estudio sobre procesos de fabricación, planes y políticas de desarrollo y costos proporciona una idea más beneficiosa de la oferta y la demanda, los precios, los ingresos, el consumo de importación / exportación y los márgenes brutos.
Se concluye la tasa de crecimiento general del mercado y la viabilidad durante el período previsible
Acerca de la tienda de investigación de mercado
En Market Research Store, proporcionamos informes sobre una variedad de industrias, como salud y farmacia, automotriz, TI, seguros, seguridad, empaque, electrónica y semiconductores, dispositivos médicos, alimentos y bebidas, software y servicios, fabricación y construcción, defensa aeroespacial. , agricultura, bienes de consumo y venta minorista, etc. Todos los aspectos del mercado están cubiertos en el informe junto con sus datos regionales. Market Research Store comprometido con los requerimientos de nuestros clientes, ofreciendo las soluciones a medida más adecuadas para el desarrollo y ejecución de la estrategia para obtener resultados sustanciales. Por encima de esto, estaremos disponibles para nuestros clientes 24 × 7.
Haga consultas / informe de compra directamente poniéndose en contacto con nosotros @ sales@marketresearchstore.com
Contáctenos:
Tienda de investigación de mercado
3422 SW 15 Street, traje # 8138,
Deerfield Beach, Florida 33442, Estados Unidos
Tel: + 1-386-310-3803GMT
Tel: + 49-322 210 92714
Sitio web: www.marketresearchstore.com